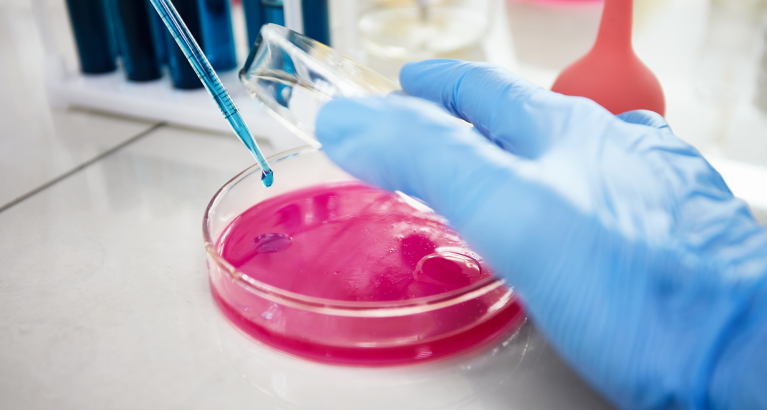

El portal Healthcare It News dio a conocer la semana anterior que el Gobierno de Reino Unido destinará más de 250 Millones de Libras para el desarrollo de investigaciones científicas en curso, que se suman al presupuesto previo de 400 Millones destinados a la Agencia de Investigación e Innovación del Reino Unido (UKRI) y a las Academias Nacionales. Con ello, el gigante europeo fortalece su posición como potencia científica en el contexto complejo de salud pública que vive el mundo.
Con esta adición de los fondos, los británicos alcanzan el mayor presupuesto para ciencia, investigación y desarrollo que han tenido en más de 40 años totalizando 17,4 Billones de Libras para el año. Se espera que el dinero sea utilizado para apoyar las investigaciones pioneras de la industria y así brindar mejores condiciones de acceso a investigadores y científicos que compiten por recursos públicos. Además, la inversión les acerca al promedio presupuestal que destinan los países de la OCDE a Innovación, ciencia y desarrollo, el cual asciende al 2.4% del PIB .
Sin duda, la noticia sienta un precedente para los países que buscan alternativas para mitigar el impacto del COVID-19 en el mundo y es una invitación a consolidar sistemas de salud que funcionen de la mano de todos los actores y procesos de innovación científica. Aunque la presión de nuevas dificultades en el ecosistema sigue creciendo, el Gobierno de Reino Unido ha dado respuesta a través de la promoción de herramientas digitales para hacer que la ciencia sea más ágil, accesible y centrada en el paciente – todo un reto para américa latina.
A pesar de ello, algunos sectores se cuestionan si realmente el Gobierno está incrementando el presupuesto. Las dudas surgen de la coyuntura sociopolítica que vive el país por cuenta del BREXIT y los fondos comunes de ciencia, investigación e innovación como Horizon. Al no pertenecer oficialmente a dichos fondos, el Gobierno debe asumir costos de membresía que, para muchos, surgen desde el mismo presupuesto para la ciencia. Es decir, en términos reales el Gobierno no estaría aumentando la inversión, sino redistribuyendo y recortando el fondo general destinado a Investigación y Desarrollo. No obstante, por ahora las comunidades científicas más importantes no han validado esas acusaciones.
Toda esta discusión, sin duda, promueve debates locales en el mundo que cuestionan la pertinencia y prioridades en los presupuestos públicos. En Colombia, por ejemplo, el presupuesto para el 2021 en Ciencia, Tecnología e Innovación no supera el 1% del PIB; una cifra que deja en mala posición al país en relación a los demás miembros de la OCDE. Y en el caso de américa latina la situación tampoco es favorable.
Lo cierto es que en un contexto tan exigente sobre los sistemas de salud en el mundo, los Gobiernos deben promover el mejoramiento de las condiciones de sus ambientes de investigación y desarrollo. Eso no solo se traduce en mayor inversión, sino también en procesos burocráticos eficientes, apertura a la participación de actores clave, corresponsabilidad en la visión del ecosistema y políticas de sostenibilidad robustas. El caso de Reino Unido es un avance en el mundo, pero persisten desafíos en todas las latitudes que aún deben afrontarse y que no dan espera.
Fuentes:
https://www.healthcareitnews.com/news/emea/uk-government-announce-extra-250m-ongoing-research
https://minciencias.gov.co/la-ciencia-en-cifras/presupuesto-colciencias